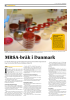
MRSA-bråk i Danmark

Alle mediene redigeres i henhold til
redaktørplakaten og vær varsom-plakaten.
redaktørplakaten og vær varsom-plakaten.
Bondebladet

Bondebladet følger den norske landbrukspolitikken fra uke til uke, og formidler nyheter av betydning for deg som driver gård og/eller er engasjert i landbruket på andre måter. Reportasjer fra hele landet gir et spennende innblikk i hva norsk landbruk er i praksis, og hvordan det drives under ulike naturgitte forhold.
Bondebladet kommer ukentlig med 40 sider i gjennomsnitt. I påska, sommerferien og jula er det dobbeltnumre.
Bondebladet kommer ukentlig med 40 sider i gjennomsnitt. I påska, sommerferien og jula er det dobbeltnumre.
Antall lesere: 127 000 (TNS Gallup MU 15.2)
Opplag: 62 954
Frekvens: 48 utgaver pr år
Bondebladet
Boks 9303 Grønland
0135 OSLO
Tlf 21 31 44 00
Faks 21 31 44 01
Ansvarlig redaktør
Iver K. Gamme
21 31 44 00
950 49 233
iver.gamme@tunmedia.no
Annonseansvarlig
Berit Clausen
21 31 44 44
97 07 06 73
berit.clausen@tunmedia.no
Utgiver:
Tun Media AS
Trykkeri:
Agderposten Trykk AS
Artikler fra mediet

Bondebladet 29.09.2016

Bondebladet 29.09.2016

Bondebladet 29.09.2016

Bondebladet 29.09.2016

Bondebladet 29.09.2016

Bondebladet 29.09.2016

Bondebladet 29.09.2016

Bondebladet 29.09.2016
Bondebladet 29.09.2016

Bondebladet 29.09.2016
Sider
Nyhetsbrev
Lag ditt eget nyhetsbrev:




































































































